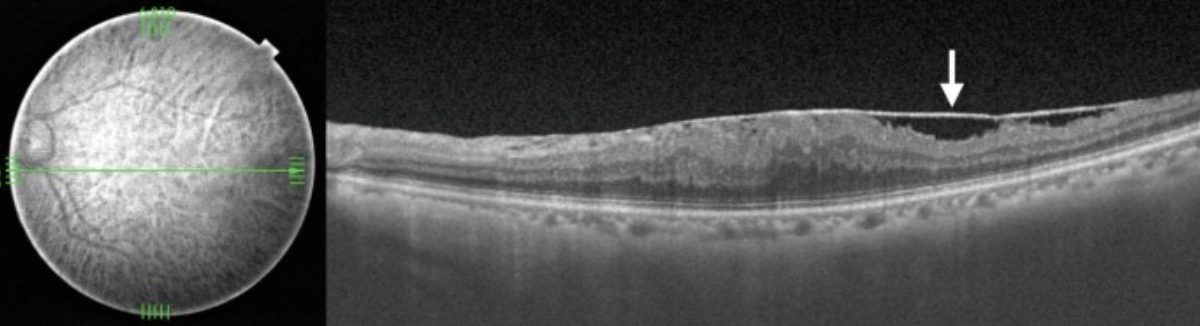

Эпиретинальный фиброз
Это образование тонкой плотной фиброзной пленки на поверхности сетчатки в макуле — эпиретинальной мембраны. Она стягивает сетчатку и образует складки. Если мембрана уплотняется и утолщается, это может привести к появлению осложнений - отекам, разрывам и расслоению сетчатки.
Часто эпиретинальный фиброз на начальных стадиях почти совсем незаметен для пациента, поскольку не приводит к существенным нарушениям зрения.
Точные причины эпиретинального фиброза неизвестны, однако заболевание возникает всегда у пациентов после 60-65 лет, и часто развивается на фоне различных офтальмологических и общих системных заболеваний, таких как: миопия высокой степени, возрастная макулярная дистрофия, сахарный диабет и др.
Диагностика
Обнаружить эпиретинальный фиброз можно при осмотре глазного дна - офтальмоскопии, в области макулы появляется так называемый “целлофановый блеск”. Но на ранних стадиях зачастую заметить его сложно, поэтому для уточнения диагноза проводят оптическую когерентную томографию сетчатки.
Лечение
На начальных стадиях эпиретинального фиброза, если зрительные функции сохранны, и нет угроз разрыва макулы или других её повреждений, рекомендуют динамическое наблюдение и консервативную терапию. При более тяжелых формах - эпиретинальную мембрану удаляют хирургическим путем. Однако, учитывая длительный период восстановления сетчатки после такой операции, прибегают к ней только при угрозах снижения зрения и прогрессирования заболевания.
Важно! В нашем офтальмологическом центре разработана уникальная схема медикаментозного лечения, которая позволяет получить выраженный положительный результат и избежать тяжелого хирургического вмешательства.























